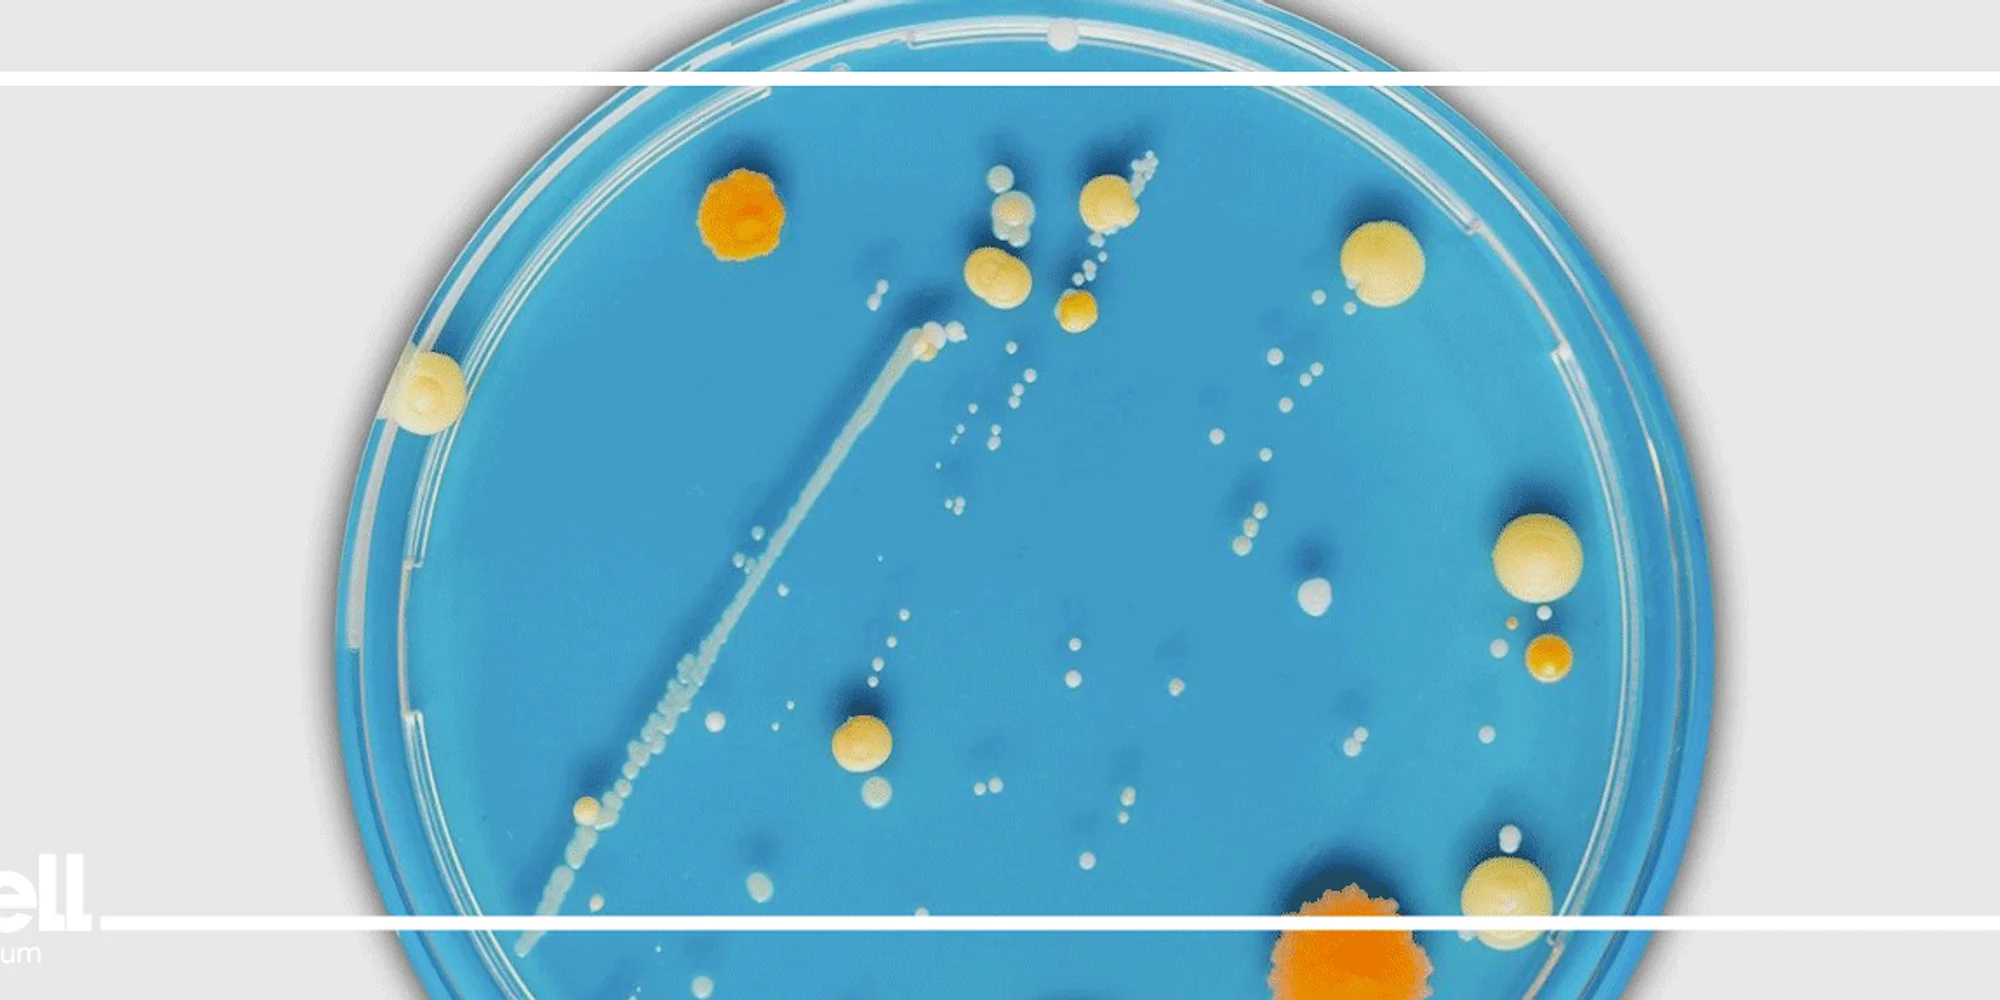

Recommended for an adult audience So-called “forever chemicals” pose a major threat to human health as PFAS has been released into the environment causing contaminated soil, water, and air. In particular, PFAS contamination in drinking water systems has been a major concern because it has been linked to increased cancer risk and reproductive problems. Despite their reputation for persistence, scientists have identified promising approaches to reducing our exposure to these chemicals and removing them from our environment. The key to a PFAS-free future may lie in understanding the biology of some of the planet’s smallest organisms. This panel will explore the threat posed by PFAS and other chemicals to the water supply, what we can do to address it, and what it will take to make it happen. Panelists Include: Cara Santelli, Associate Professor, Department of Earth and Environmental Sciences, College of Science and Engineering Matt Simcik, Professor in the Division of Environmental Health Sciences in the School of Public Health Larry Wackett, Professor, Department of Biochemistry, Molecular Biology and Biophysics, College of Biological Sciences Registration is requested. Doors open at 5:45 p.m. Program starts at 6:15 p.m. Register Here Petri Dish panel discussions explore how biology affects our lives and what it means for our future. No PowerPoints. Just lively, curiosity-driven conversations on timely topics with University of Minnesota experts. Organized by the University of Minnesota’s College of Biological Sciences In collaboration with the Bell Museum.
We are about curiosity, wonder, nature, & the universe. Journey through time & space in our museum & planetarium. #bellmuseum